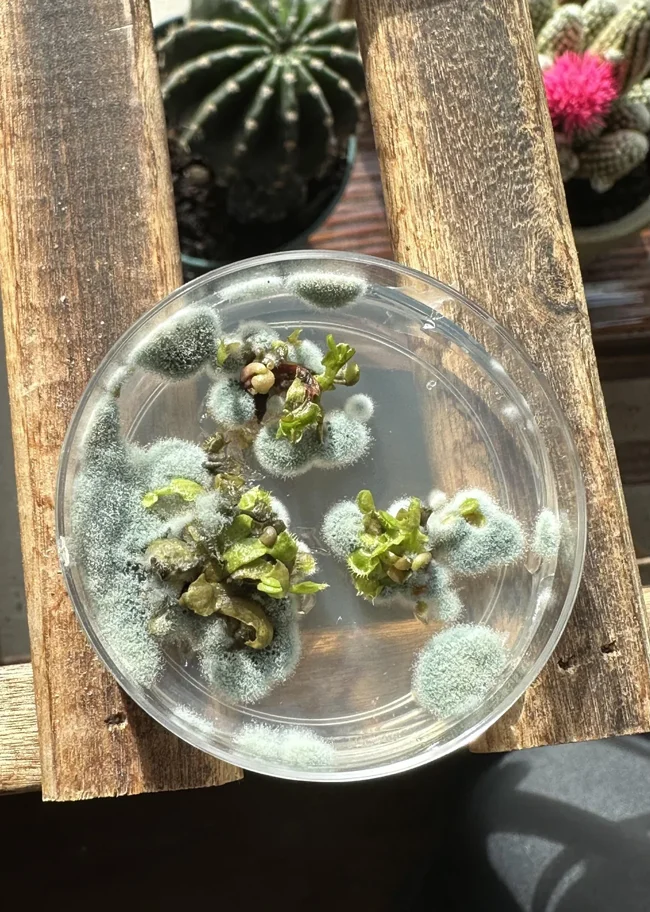

13 випадків, коли люди забули про щось на довгий час, а потім виявили чудову плісняву (14 фото)
Ці люди не тільки діляться знімками химерної плісняви, але й намагаються розпізнати її вигляд і допомогти позбутися її. 
Навіть найохайніші і акуратніші колись стикалися з пліснявою. Це досить живучі гриби, які непомітно з'являються усюди, де є вологість та поживні речовини. Перша і найрозумніша реакція при зіткненні з пліснявою, звичайно, прибирання. Але перш ніж впоратися з цією неприємністю деякі користувачі мережі вважають за краще похвалитися знайденою рослинною живністю у вигляді фотографій в інтернеті. Це може здатися дивним, поки не побачиш ті самі фотографії, де пліснява набуває найнесподіваніших форм і кольорів, а також з'являється в найнесподіваніших місцях.
Мені дали відростки мухоловки, але вона трохи здичала
У коментарях до цієї фотографії припустили, що це може бути триходерма, дуже плідна садова пліснява.
Залишила ці кокоси у контейнері та приблизно на тиждень забула про них. Вони виглядають такими пухнастими і м'якими! 
Гарбуз незвичайної форми, залишений з листопада 
Як не дивно, ми купили два гарбузи одночасно, але з іншого все гаразд.
Ніжна лососьово-рожева цвіль на цьому крем-фреші 
Ого, я спочатку подумав, що то ікра.
В інших коментаторів знайшлися асоціації з прищами та цукерками, які вибухають прямо мовою. А вам що нагадав цей вид плісняви?
Зелена волохата цвіль на шматочках свинини, яку забули в холодильнику 
Скушкірний апельсин 
Я бачив запліснявілі апельсини, які стали м'якими і зеленими, цей виявився дуже твердим на дотик і білим.
Волоски у м'ятному сиропі 
У коментарях знайшлися знавці, які припустили, що це може бути не пліснява, а кристалізований цукор. Але з'ясувати це, напевно, може тільки господар пляшки.
Тільки зелена гуаш згодом заплісніла і перетворилася на пухнасту грудочку. 
Червоний геотрихум на забутих макаронах 
Я знаю про це лише з вирощування грибів. Це дуже проблемна яскраво-червона токсична пліснява, з якою ви не захочете мати нічого спільного.
Забутий часниковий соус 
Я забув у холодильнику цей часниковий соус із грецького йогурту… він був у такому вигляді, коли я повернувся після тритижневої відпустки.
Рівно по діаметру 
Ні, це не бабусина розсада 
Мій холодильник погано працював останній тиждень, і ось, що трапилося зі старою банкою котячого корму.
Духовка, припорошена снігом 
Як ти до такого дійшов? Чи забув їжу на місяць?
Насправді їй менше тижня. Я приготувала солодку картоплю та забула кілька штук.
